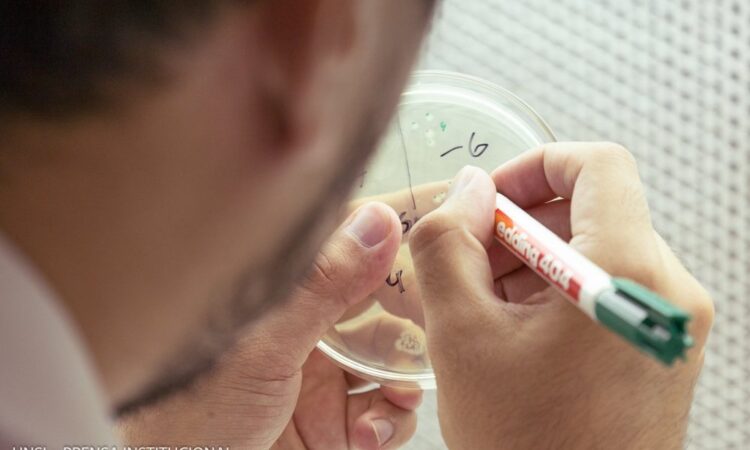
UNSL: CONVOCAN A LA CATEGORIZACIÓN DE DOCENTES INVESTIGADORES UNIVERSITARIOS

En el marco del Día del Investigador Científico y Tecnológico que se celebra el 10 de abril, el Ministerio de Educación de la Nación a través de la Secretaría de Políticas Universitarias (SPU), abrió la convocatoria para la categorización de docentes investigadores de todo el sistema universitario argentino. La inscripción cierra el 31 de mayo.
Cada 10 de abril se celebra el Día de la investigadora y el investigador científico argentino en conmemoración al nacimiento del Dr. Bernardo Houssay, primer galardonado con el Premio Nobel en Ciencias de América Latina e impulsor de la creación del Consejo Nacional de Investigaciones Científicas y Técnicas (CONICET).
En el marco de esta fecha que marcara un antes y un después en el desarrollo de la ciencia en nuestro país, y reconociendo a quienes hoy trabajan para sumar conocimientos que contribuyan al desarrollo económico y el progreso social de nuestro país, es que la SPU lanza una convocatoria a docentes-investigadores con el objetivo de fortalecer su figura dentro del sistema universitario.
La importancia de la investigación científica universitaria
Un gran porcentaje de las investigaciones científicas se realizan dentro del sistema universitario. Esto se vio claramente durante la pandemia provocada por el Covid-19, donde diversos grupos multidisciplinarios pudieron dar rápidas respuestas a esta emergencia sanitaria, redireccionando investigaciones de años. Como esto, centenas de desarrollos se generan en los distintos nodos de investigación en todas las universidades del país, los cuales permiten dar respuestas a diversas problemáticas sociales en las más variadas áreas de conocimiento con un enfoque regional.
Los procesos de categorización se iniciaron hace ya 30 años y contribuyeron a otorgar identidad institucional a la investigación en las universidades nacionales con el «docente-investigador». De la experiencia de la última categorización emergieron diferentes cuestiones a atender para futuras categorizaciones, entre otras, que la mayor cantidad de mujeres se encontraban en las categorías más bajas, y que en las categorías más altas los investigadores pertenecían a las Ciencias Exactas y Naturales.
Es por ello que la Secretaría de Políticas Universitarias junto a las universidades argentinas, comenzó a trabajar en una agenda de siete (7) puntos entre los cuales se destaca el eje Carrera de Investigador Universitario, con el objetivo de institucionalizar la figura de la investigadora y el investigador de universidades públicas y privadas, contemplando criterios que favorezcan la igualdad de género, el federalismo y la autonomía, atendiendo las líneas propuestas por las universidades y las políticas nacionales de desarrollo del conocimiento.
En el mes de marzo se presentó el Programa para la investigación universitaria argentina (Prinuar) y ahora se lanza la convocatoria que permitirá la categorización y la recategorización de docentes investigadores de todo el sistema universitario, resolviendo así las situaciones de atraso en las categorías y permitiendo la incorporación a la carrera científica de nuevos/as docentes.
Sobre la convocatoria
Esta iniciativa está dirigida a docentes que realizan actividades de I+D o en artes, tanto en instituciones universitarias de gestión estatal (pública) como privada y que deseen ingresar al programa o quieran promocionar o permanecer; a los/as cuales se les asignará categorías en función de los antecedentes y logros en sus trayectorias individuales.
Para definirlas, se tuvo en cuenta los trabajos realizados y los consensos alcanzados entre actores del sistema universitario (CIN y CRUP) como así también de la Secretaría de Articulación Científica y Tecnológica del MINCyT.
Para devolver la previsibilidad a las carreras de los/as docentes, como así también a la política y planificación de la función de I+D al interior de cada universidad, la SPU definió además una periodicidad de las incorporaciones y de las evaluaciones de actividad, proponiendo convocatorias cada dos (2) años en ingreso y promoción, y cada cuatro (4) años para la permanencia.
De esta manera, se busca reconocer el trabajo de dichos/as profesionales y, asimismo, influenciar en las elecciones que realizan los/as docentes universitarios/as, ya sea en su empleo del tiempo como en las estrategias de avance en sus carreras.
Las y los interesadas/os podrán ingresar aquí.
Fuente: Ministerio de Educación de la Nación
Foto: archivo Prensa UNSL